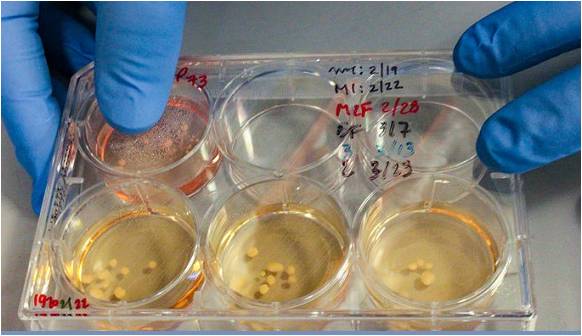

|
| Nova descoberta. A atividade elétrica dos mini-cérebros estudados no Laboratório do Dr. Alysson Muotri, podem ser comparados a um recém-nascido |
tudo muito, muito, muito fantástico! Torcendo muito pelo sucesso do estudo e pesquisas, e que tudo seja usado para o Bem, como a utilização para cura de doenças como autismo, esquizofrenia, mal de Alzheimer. Organoides no espaço. Acompanhando com grande interesse o desenvolvimento de tudo.
Transcrito de UOL:
Pequenos organoides humanos semelhantes a "minicérebros" primitivos foram enviados pela NASA à Estação Espacial Internacional e os primeiros resultados sugerem que eles estariam produzindo ondas cerebrais simples. O feito fez os cientistas se questionarem se esses "minicérebros" seriam realmente incapazes de produzir consciência, como se acreditava até então. O brasileiro Alysson Muotri é quem encabeça essa pesquisa na Universidade da Califórnia em San Diego, nos Estados Unidos. Em entrevista ao jornal "The New York Times", ele explica que os organoides (termo correto para "minicérebros") foram desenvolvidos a partir de pele humana em células-tronco e induzidos a se desenvolverem como células cerebrais em um embrião.
Em julho, a agência espacial americana NASA colocou esses organoides em um foguete e os enviou à Estação Espacial Internacional (ISS na sigla em inglês). O objetivo é ver como eles se desenvolvem em um ambiente de gravidade zero. Colocados dentro de uma caixa de metal, os astronautas da estação os alimentam com caldo nutritivo. "Eu acho que eles estão se replicando como loucos neste estágio e, portanto, teremos organoides maiores", disse em Muotri ao jornal americano. Na última quinta-feira, a equipe de Muotri publicou na Cell Steam Cell um relatório no qual aponta que os organoides estão produzindo ondas cerebrais simples.
Em cérebros humanos maduros, essas ondas são produzidas por complexas redes de neurônios que trabalham em sincronia. Cada tipo de onda produz uma atividade cerebral diferente, como sonhar ou recordar. Os cientistas também perceberam que os organoides estão amadurecendo e as ondas mudando, se assemelhando ao comportamento de um cérebro de bebê prematuro.
Embora produzidos com células humanas e semelhantes a cérebros, cientistas enfatizam que esses organoides não são cérebros de verdade, portanto, incapazes de ter consciência. A descoberta de Muotri e sua equipe, no entanto, pode fazer os cientistas repensarem esta crença.
"Alguns de meus colegas dizem: 'Não, essas coisas nunca serão conscientes'. Agora não tenho tanta certeza - Alysson Muotri ao NYT
|
| minicérebros (organóides) feitos a partir de células tronco de neandertais |
Ao NYT, o cientista chefe e presidente do Allen Brain Institute em Seattle, Christof Koch, explicou que a produção de organoides conscientes pode representar uma séria preocupação ética à ciência. "Quanto mais chegamos ao seu objetivo, maior a probabilidade de termos um cérebro capaz de senciência e de sentir dor, agonia e angústia", disse Koch.
Os organoides têm sido utilizados pela ciência para estudar o cérebro humano. Há um ano, Alysson Muotri contou ao UOL como colocou "minicérebros" de neandertais em robôs para ensiná-los a andar.
O objetivo era compreender como se dá o desenvolvimento do cérebro humano e identificar alterações neurológicas ligadas a patologias como autismo, por exemplo. É para tornar estes estudos mais precisos que Moutri quer desenvolvê-los o mais próximo possível de um cérebro humano maduro. Por isso os organoides foram inseridos em robôs e agora enviados ao espaço.
Na estação espacial, a caixa onde estão os "minicérebros" é um protótipo de um dispositivo que algum dia poderá produzir organoides sem intervenção humana. Os astronautas apenas instalaram a caixa, ligaram a energia e a deixam funcionar sozinha.
Ela possui uma câmera por dentro que tira fotos a cada trinta minutos as quais que tira fotos a cada trinta minutos as quais Muotri pode monitorar de San Diego. Nas imagens, ele vê meia dúzia de esferas cinzas flutuando sobre um fundo bege, descreveu o NYT.
"Eles são arredondados e têm mais ou menos o mesmo tamanho", disse Muotri. "Você não os vê se fundindo ou se agrupando. Então, essas são todas boas notícias". Ele disse que não se importa em ver se este experimento — fazer organoides em massa sem auxílio humano — tornar o seu trabalho em produzi-los obsoleto. "Acho que podemos usar nosso cérebro para algo mais nobre", termina.
https://www.uol.com.br/tilt/noticias/redacao/2019/09/04/cientistas-enviam-minicerebros-ao-espaco-e-detectam-atividades-cerebrais.htm?utm_source=chrome&utm_medium=webalert&utm_campaign=ciencia-e-saude
https://www.youtube.com/watch?v=rbqwjpbhB_s
Link neste blog: https://tdahcriancasquedesafiam.blogspot.com/2019/09/autismo-e-outras-doencas-minicerebros.html
LEIA TAMBÉM:
Modafinil, Stavigile no Brasil, proibido para crianças. Riscos altos demais – Drs. Ahmed Dahir Mohamed e Alysson Muotri
 |
| Modafinil, Stavigile no Brasil, comercializada também como Provigil, Vigil, Modioda, Modavigil, Vigicer. Nos EUA, os riscos foram considerados altos demais e o medicamento foi proibido para crianças. |
Publicado no blog TDAH CRIANÇAS QUE DESAFIAM em 27.abril.2017
http://tdahcriancasquedesafiam.blogspot.com.br/2017/04/sobre-o-uso-de-modafinil-e-ritalina-em.html
http://tdahcriancasquedesafiam.blogspot.com.br/2017/04/sobre-o-uso-de-modafinil-e-ritalina-em.html
 Marise Jalowitzki é educadora, escritora, blogueira e colunista. Palestrante Internacional, certificada pelo IFTDO - Institute of Federations of Training and Development, com sede na Virginia-USA. Especialista em Gestão de Recursos Humanos pela Fundação Getúlio Vargas. Criou e coordenou cursos de Formação de Facilitadores - níveis fundamental e master. Coordenou oficinas em congressos, eventos de desenvolvimento humano em instituições nacionais e internacionais, escolas, empresas, grupos de apoio, instituições hospitalares e religiosas por mais de duas décadas Autora de diversos livros, todos voltados ao desenvolvimento humano saudável. marisejalowitzki@gmail.com
Marise Jalowitzki é educadora, escritora, blogueira e colunista. Palestrante Internacional, certificada pelo IFTDO - Institute of Federations of Training and Development, com sede na Virginia-USA. Especialista em Gestão de Recursos Humanos pela Fundação Getúlio Vargas. Criou e coordenou cursos de Formação de Facilitadores - níveis fundamental e master. Coordenou oficinas em congressos, eventos de desenvolvimento humano em instituições nacionais e internacionais, escolas, empresas, grupos de apoio, instituições hospitalares e religiosas por mais de duas décadas Autora de diversos livros, todos voltados ao desenvolvimento humano saudável. marisejalowitzki@gmail.com 
Nenhum comentário:
Postar um comentário